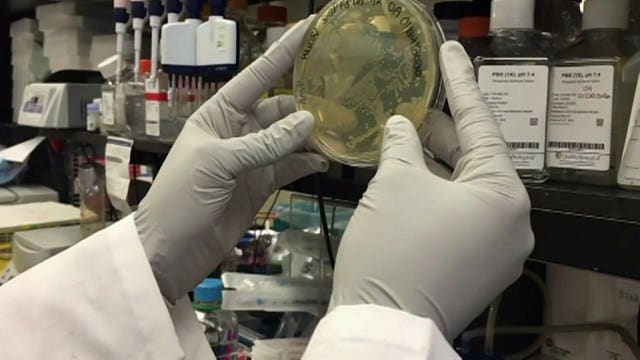
MHD can test '25-30 specimens a day' for coronavirus; federal funding could expand testing

'This is about saving lives:' Milwaukee officials urge awareness as virus cases rise
MILWAUKEE -- As the coronavirus continues to spread from person to person in Milwaukee at a high rate, the city's health department and other leaders have come up with meaningful messages.A series of PSAs launched by the Milwaukee Health Department is designed to increase awareness and share ways to stay healthy.City health leaders on Thursday night, March 26 said the largest concentrations of cases were in the central city and north side neighborhoods with a high density of African-American residents.
MILWAUKEE -- As the coronavirus continues to spread from person to person in Milwaukee at a high rate, the city's health department and other leaders have come up with meaningful messages.A series of PSAs launched by the Milwaukee Health Department is designed to increase awareness and share ways to stay healthy.City health leaders on Thursday night, March 26 said the largest concentrations of cases were in the central city and north side neighborhoods with a high density of African-American residents.
Orders issued to curb COVID-19 spread, Milwaukee County officials stress staying home
MILWAUKEE -- As cities turn into ghost towns, people are urged to limit interactions to five people total and trips outside the home are asked to be limited to essential needs.While flagrantly flouting the state order could lead to law enforcement stepping in, the punishment of not following the order could be far worse.
MILWAUKEE -- As cities turn into ghost towns, people are urged to limit interactions to five people total and trips outside the home are asked to be limited to essential needs.While flagrantly flouting the state order could lead to law enforcement stepping in, the punishment of not following the order could be far worse.
'1st time I've been out of the house:' Voters cast ballots in drive-through in Richfield amid COVID-19
RICHFIELD -- Voting advocacy groups and the mayor of Milwaukee, Wisconsin's largest city, on Tuesday, March 24 urged Gov.
RICHFIELD -- Voting advocacy groups and the mayor of Milwaukee, Wisconsin's largest city, on Tuesday, March 24 urged Gov.
Milwaukee health officials target 'mainly the African American community' to stop COVID-19
MILWAUKEE -- Milwaukee health officials on Monday, March 23 said a majority of the positive COVID-19 cases live on Milwaukee's north side, and that they planned on sending outreach teams into neighborhoods to ask people to go home in an effort to stop the spread."I wanna make sure that our residents, particularly on the northern part of the city, are listening to what I'm saying," said Milwaukee Mayor Tom Barrett. "Please, please, please do everything you can to keep your distance, literally, from other individuals.
MILWAUKEE -- Milwaukee health officials on Monday, March 23 said a majority of the positive COVID-19 cases live on Milwaukee's north side, and that they planned on sending outreach teams into neighborhoods to ask people to go home in an effort to stop the spread."I wanna make sure that our residents, particularly on the northern part of the city, are listening to what I'm saying," said Milwaukee Mayor Tom Barrett. "Please, please, please do everything you can to keep your distance, literally, from other individuals.
Milwaukee mayor suggests April 7 election be modified to 'vote by mail'
MILWAUKEE -- Milwaukee Mayor Tom Barrett sent a letter Monday, March 23 to Gov.
MILWAUKEE -- Milwaukee Mayor Tom Barrett sent a letter Monday, March 23 to Gov.
City of Milwaukee issues 'Stay at Home' order effective Wednesday: 'It is not to alarm anyone'
MILWAUKEE -- Milwaukee Mayor Tom Barrett announced on Monday, March 23 that the city is issuing a "Stay at Home" order that will be in effect starting at midnight -- Wednesday morning, March 25.
MILWAUKEE -- Milwaukee Mayor Tom Barrett announced on Monday, March 23 that the city is issuing a "Stay at Home" order that will be in effect starting at midnight -- Wednesday morning, March 25.
'You are safer at home:' Milwaukee County officials stress need for 'social distancing'
MILWAUKEE -- With three deaths in Wisconsin and a growing number of confirmed cases of the coronavirus in Milwaukee County, officials stressed the importance of maintaining social distancing, the importance of isolation, and avoiding all non-essential contact with others.As of Friday afternoon, March 20, there are 95 confirmed cases of COVID-19 in Milwaukee County.
MILWAUKEE -- With three deaths in Wisconsin and a growing number of confirmed cases of the coronavirus in Milwaukee County, officials stressed the importance of maintaining social distancing, the importance of isolation, and avoiding all non-essential contact with others.As of Friday afternoon, March 20, there are 95 confirmed cases of COVID-19 in Milwaukee County.
'We'll get through this:' Milwaukee mayor in self-quarantine, exposed to person with coronavirus
MILWAUKEE -- Milwaukee Mayor Tom Barrett said he feels fine and his office at City Hall is closed.
MILWAUKEE -- Milwaukee Mayor Tom Barrett said he feels fine and his office at City Hall is closed.
Milwaukee Mayor Tom Barrett in self-quarantine, came in contact with person who tested positive
MILWAUKEE -- In a statement shared Thursday, March 19, Milwaukee Mayor Tom Barrett announced that he is in self-quarantine.
MILWAUKEE -- In a statement shared Thursday, March 19, Milwaukee Mayor Tom Barrett announced that he is in self-quarantine.
Employee of Milwaukee Co. Election Commission tests positive for COVID-19; 64 cases reported in county
MILWAUKEE -- An employee of the Milwaukee County Election Commission has tested positive for the coronavirus, county officials announced on Thursday, March 19.Milwaukee County Clerk George Christenson indicated the individual, over age 60, has not been in the Milwaukee County Courthouse since Tuesday, March 10.
MILWAUKEE -- An employee of the Milwaukee County Election Commission has tested positive for the coronavirus, county officials announced on Thursday, March 19.Milwaukee County Clerk George Christenson indicated the individual, over age 60, has not been in the Milwaukee County Courthouse since Tuesday, March 10.
Milwaukee Mayor Tom Barrett running for re-election amid coronavirus pandemic: 'A true crisis'
MILWAUKEE -- Milwaukee Mayor Tom Barrett is leading the city's response to the coronavirus as he faces a re-election bid.
MILWAUKEE -- Milwaukee Mayor Tom Barrett is leading the city's response to the coronavirus as he faces a re-election bid.
Evidence of 'community transmission' of COVID-19 in Milwaukee
MILWAUKEE -- Milwaukee Health Commissioner Jeanette Kowalik revealed on Monday, March 16 evidence of community transmission (meaning the transmission was not the result of travel or direct contact with a known carrier) of the coronavirus in the City of Milwaukee.
MILWAUKEE -- Milwaukee Health Commissioner Jeanette Kowalik revealed on Monday, March 16 evidence of community transmission (meaning the transmission was not the result of travel or direct contact with a known carrier) of the coronavirus in the City of Milwaukee.
'Working around the clock:' Milwaukee officials preparing for coronavirus cases, more tests
MILWAUKEE -- City of Milwaukee health officials said in an address Thursday, March 12 that there will not be mandatory school or business closures due to coronavirus at this time.While not mandating closures, the city echoed the state's call for any event involving 250 people or more to be canceled as a way to prevent the community spread of the virus.
MILWAUKEE -- City of Milwaukee health officials said in an address Thursday, March 12 that there will not be mandatory school or business closures due to coronavirus at this time.While not mandating closures, the city echoed the state's call for any event involving 250 people or more to be canceled as a way to prevent the community spread of the virus.
MHD can test '25-30 specimens a day' for coronavirus; federal funding could expand testing
MILWAUKEE -- Milwaukee Mayor Tom Barrett, health officials, and other leaders on Sunday, March 8 offered an update on the fight against coronavirus -- focused on preparedness, with no cases in Milwaukee or Milwaukee County."We want to be prepared as we can be," said Mayor Barrett. "We have been working closely with the state, and the state has been working closely with the CDC."As of Friday, March 6, officials with the Wisconsin Department of Health Services announced 12 pending tests for coronavirus -- a total of 31 negative tests, and just one positive test in the state -- a Dane County resident who returned from China and was placed under quarantine at the end of January.
MILWAUKEE -- Milwaukee Mayor Tom Barrett, health officials, and other leaders on Sunday, March 8 offered an update on the fight against coronavirus -- focused on preparedness, with no cases in Milwaukee or Milwaukee County."We want to be prepared as we can be," said Mayor Barrett. "We have been working closely with the state, and the state has been working closely with the CDC."As of Friday, March 6, officials with the Wisconsin Department of Health Services announced 12 pending tests for coronavirus -- a total of 31 negative tests, and just one positive test in the state -- a Dane County resident who returned from China and was placed under quarantine at the end of January.
Leaders announce 'largest solar energy system in Milwaukee’s history;' will power 460 homes
MILWAUKEE -- Milwaukee Mayor Tom Barrett and officials with the City of Milwaukee’s Environmental Collaboration Office on Tuesday, March3 announced plans to build "the largest solar energy system in Milwaukee’s history." The eight-acre project will be located on a city-owned parcel near Milwaukee Mitchell International Airport."Today, I'm pleased to announce that we're working with We Energies to build the largest solar project in the City of Milwaukee," said Mayor Barrett.The project, on the edges of an old landfill, will provide enough energy to light up more than 460 homes.
MILWAUKEE -- Milwaukee Mayor Tom Barrett and officials with the City of Milwaukee’s Environmental Collaboration Office on Tuesday, March3 announced plans to build "the largest solar energy system in Milwaukee’s history." The eight-acre project will be located on a city-owned parcel near Milwaukee Mitchell International Airport."Today, I'm pleased to announce that we're working with We Energies to build the largest solar project in the City of Milwaukee," said Mayor Barrett.The project, on the edges of an old landfill, will provide enough energy to light up more than 460 homes.
Milwaukee monitoring 4 people for possible exposure to coronavirus; cases not confirmed
MILWAUKEE -- Milwaukee is currently monitoring four people who recently returned from China for coronavirus.
MILWAUKEE -- Milwaukee is currently monitoring four people who recently returned from China for coronavirus.